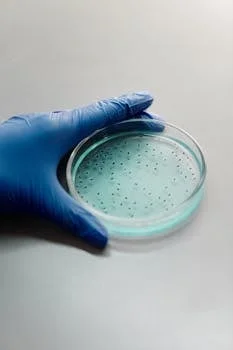
板框压滤机 - 板框压滤机2026年市场价格参考与成本控制建议

板框压滤机选型第一步:搞清楚过滤面积和处理量的匹配关系
板框压滤机选型需综合3个核心维度:过滤面积(㎡)、滤板材质、处理量匹配。以常规市政污泥为例,固体浓度1-3%的泥浆,处理100m³/d需过滤面积约200-400㎡,对应1250型或2000型机型;滤板材质首选聚丙烯(耐酸碱,适用pH 2-12),含强酸强碱工况选不锈钢覆膜。选错规格会导致滤饼含水率超标(设计值≤60%)或处理周期过长(正常压滤周期45-90分钟/批次)。
过滤面积计算遵循公式:所需过滤面积(㎡) = 处理量Q(m³/d) ÷ 批次处理时间T(h) × 安全系数K(1.2-1.5)。固体浓度1-3%的市政污泥,每㎡过滤面积处理量约0.5-1.2m³/h(依据行业工程经验值)。安全系数K取值1.2-1.5,用于应对污泥浓度波动、设备维护停机、物料性质变化等工况不确定性。
机型规格与处理量的对应关系决定了选型的第一道门槛。250型过滤面积约20-50㎡,适用处理量5-20m³/d;630型过滤面积约80-150㎡,适用处理量20-50m³/d;1250型过滤面积约200-500㎡,适用处理量50-200m³/d;2000型过滤面积约800-1200㎡,适用处理量200m³/d以上大型市政或工业污泥站。
| 机型规格 | 过滤面积(㎡) | 适用处理量(m³/d) | 典型应用场景 |
|---|---|---|---|
| 250型 | 20–50 | 5–20 | 小型实验室、食品加工废水 |
| 630型 | 80–150 | 20–50 | 中小型工业废水站 |
| 1250型 | 200–500 | 50–200 | 市政污泥、中大型工业污泥 |
| 2000型 | 800–1200 | ≥200 | 大型市政污水厂、工业园区集中处理 |
压滤周期直接影响设备产能利用率。污泥含水率80%时,单批次压滤时间45-90分钟;含水率降至60%需额外增加20-40分钟压榨时间。以日处理量100m³/d为例,若每批次处理8m³泥浆、周期90分钟,则每日需完成约13批次,工作时间约20小时,已接近两班制运行极限,此时应考虑选型上浮一档或增加压滤机台数。
滤板材质对比:PP/不锈钢/铸铁/橡胶覆膜怎么选
滤板材质直接决定设备耐化学性、适用温度范围和采购成本,是选型中最易踩坑的决策点。选错材质轻则滤板寿命缩短,重则引发滤液泄漏、安全事故。
聚丙烯(PP)滤板市场占有率约60%,耐酸碱范围pH 2-12,耐温上限80℃,造价比金属材质低30-50%,适合化工、印染、制药大多数废水处理工况。PP滤板弱点在于耐有机溶剂性能有限,且长期承受高压后存在蠕变风险,额定过滤压力一般不超过1.0MPa。
不锈钢(304/316L)滤板耐强酸强碱,耐温可达120℃,造价比PP高40-60%,适用于电子、冶金湿法冶炼等高腐蚀工况。316L相比304添加了钼元素,对氯离子耐受性更强,是含盐废水、沿海地区项目的首选。需要注意的是,不锈钢滤板并非完全免维护,长期接触高浓度氯离子仍可能产生点蚀。
铸铁覆膜滤板机械强度最高,耐磨耐压,适用于矿山、河道清淤等高固体浓度(SS>5g/L)、含硬质颗粒的泥浆工况。橡胶覆膜(板框隔膜压滤机)通过向滤板隔膜内注入压缩空气或水,实现二次压榨,压榨压力可达1.5-2.0MPa,泥饼含水率可比普通板框再降5-10个百分点。中节能国祯环保科技股份有限公司项目数据显示,SSD化学改性结合板框隔膜压滤机可将污泥脱水至≤60%。
| 滤板材质 | 耐化学性(pH范围) | 耐温上限 | 过滤压力 | 参考价格系数 | 典型适用场景 |
|---|---|---|---|---|---|
| 聚丙烯(PP) | 2–12 | 80℃ | ≤1.0 MPa | 1.0× | 常规工业废水、市政污泥 |
| 不锈钢304 | 1–14(广谱) | 120℃ | ≤1.6 MPa | 1.4–1.6× | 酸碱交替工况、高温废水 |
| 不锈钢316L | 1–14(耐氯) | 120℃ | ≤1.6 MPa | 1.5–1.8× | 含盐废水、海水淡化 |
| 铸铁覆膜 | 4–10 | 100℃ | ≤2.0 MPa | 1.2–1.4× | 高固体浓度、含颗粒泥浆 |
| 隔膜压滤机 | 依基材而定 | 依基材而定 | 1.5–2.0 MPa | 1.5–2.0× | 需极低含水率污泥深度脱水 |
选材判断树可快速定位适合方案:pH11强碱环境选不锈钢或PP覆膜;常规市政/工业废水(pH 5-9)选PP性价比最高;污泥含水率目标≤50%必须选隔膜压滤机。更多规格参数可参考X(B)系列板框压滤机(滤板尺寸450-1500mm,液压/PLC全自动多配置)的技术选型表。
自动化程度选择:手动/液压/PLC全自动的经济性对比

自动化程度选择直接影响设备价格、运营成本和人工依赖度。采购经理需要在设备投资与长期运行成本之间找到平衡点,而非盲目追求最高配置。
手动拉板型价格最低,适合处理量
液压半自动型(自动压紧/松开,手动拉板)是目前市场主流选择,价格适中,适合处理量20-100m³/d的工业废水站。设备自动完成压紧保压流程,人工只需操作拉板小车和卸饼动作,单批次人工工时降至0.5-1h,滤饼均匀性显著提升。
PLC全自动型实现压紧→进料→压榨→拉板→卸饼全流程自动化,适合处理量>100m³/d或需要24h连续运行的工况。设备溢价约30-45%,但人工成本可减少70%以上。全自动机型泥饼含水率批次偏差≤3%,过滤效果高度一致。深水生态板框压滤机维修服务采购项目(2026年4月)显示,处理量较大的工况倾向于采购全自动机型以降低长期运营成本。
| 自动化等级 | 自动化环节 | 人工工时/批次 | 适用处理量 | 价格参考 | 滤饼均匀性 |
|---|---|---|---|---|---|
| 手动拉板型 | 无 | 1.5–2 h | 基准价 | 偏差>20% | |
| 液压半自动型 | 压紧/松开 | 0.5–1 h | 20–100 m³/d | 基准价×1.3 | 偏差10–15% |
| PLC全自动型 | 全流程自动 | 0.1–0.2 h | ≥100 m³/d | 基准价×1.5 | 偏差≤3% |
污泥含水率目标≤50%时,强烈建议选PLC全自动+隔膜压榨组合机型。手动操作难以精准控制压榨时间和压力,过度压榨易损坏滤板,压力不足则含水率不达标。自动化系统可通过压力传感器和PLC反馈控制,确保每批次压榨曲线一致。
3个典型行业的板框压滤机选型方案对比
选型逻辑需要结合具体行业工况验证。以下3个案例覆盖了采购经理最常遇到的工业废水类型,每个案例均给出具体机型、配置方案和过滤效果数据。
案例1——造纸废水:固体浓度1.5-2.5%,纤维含量高,pH 6-9。推荐1250型PP滤板液压自动型,滤饼含水率45-55%,每批次处理约4m³泥浆。造纸废水纤维易缠绕滤布,需选用抗堵塞型滤布并缩短冲洗周期。详细工艺参数可参考造纸废水板框压滤机工艺参数匹配方案。
案例2——陶瓷厂污泥:高浓度泥浆,含水率80%以上需脱水至30-50%,滤饼呈颗粒状便于后续制砖。推荐全自动板框隔膜压滤机,压榨压力1.5MPa。陶瓷污泥固体密度高,滤饼重量大,需加强滤板承重结构和卸饼斜度设计。泥浆不落地隔膜压滤机可实现从进料到泥饼装车的全封闭处理,符合环保要求。
案例3——化工废水(制药/印染):含COD 500-2000mg/L,pH波动大,可能含重金属离子。推荐不锈钢316L滤板全自动型,配套加药装置调节pH后再进料。重金属废水对金属滤板有腐蚀风险,316L材质相比304耐氯离子点蚀性能提升约40%,适合含盐量较高的精细化工废水。
| 行业 | 关键工况特征 | 推荐机型 | 滤板材质 | 自动化等级 | 滤饼含水率 |
|---|---|---|---|---|---|
| 造纸废水 | 高纤维、pH 6-9 | 1250型 | 聚丙烯 | 液压半自动 | 45–55% |
| 陶瓷厂污泥 | 高浓度颗粒、需制砖 | 1250型隔膜 | 铸铁覆膜 | PLC全自动 | 30–50% |
| 化工废水 | 含重金属、pH波动 | 1250型 | 不锈钢316L | PLC全自动 | 50–60% |
3个案例的共同规律:处理量>50m³/d均选1250型以上,腐蚀性工况均升级不锈钢或隔膜滤板。选型时首先根据日处理量锁定机型规格,再根据水质特性确定滤板材质,最后根据预算和自动化需求确定控制方式。
板框压滤机2026年市场价格参考与成本控制建议
板框压滤机价格受机型规格、自动化程度、滤板材质三因素叠加影响,价差可达数倍。以下价格区间为市场调研参考值,实际成交价需结合项目配套要求和供应商报价确定。
1250型液压半自动型市场价18-35万元,具体价格取决于滤板材质(PP vs 不锈钢)和配套附件(滤布冲洗系统、自动加药装置)。2000型PLC全自动隔膜压滤机市场价50-120万元,配件和滤布消耗约2-5万元/年。深水生态板框压滤机维修服务采购项目(2026年4月,中标价105万元)显示,大型设备含全包服务的综合成本更高但运行保障更强。
滤布是耗材成本的主要构成。常规工况下滤布更换周期3-6个月,高磨蚀工况(如含砂量高的河道清淤污泥)缩短至1-2个月。每套滤布价格约2000-8000元,根据滤板数量和规格而定。年耗材成本可按"处理量(万m³/d) × 滤布单价 × 年更换次数"估算。
| 机型规格 | 自动化等级 | 滤板材质 | 价格区间(万元) | 年耗材成本(万元) | 主机寿命 |
|---|---|---|---|---|---|
| 1250型 | 液压半自动 | PP | 18–28 | 1–3 | 15–20年 |
| 1250型 | PLC全自动 | 不锈钢316L | 35–55 | 2–4 | 15–20年 |
| 2000型 | PLC全自动隔膜 | 不锈钢316L | 50–120 | 3–6 | 15–20年 |
设备使用寿命方面,正常使用和维护下,主机寿命15-20年,液压系统8-12年,PLC控制系统5-8年。采购时需将控制系统折旧纳入全生命周期成本计算,避免低价采购高价维护的陷阱。
常见问题
板框压滤机过滤面积怎么根据处理量计算?
过滤面积(㎡) = 处理量(m³/h) ÷ 单位面积处理量(0.5-1.2㎡·h/m³) × 安全系数1.2。100m³/d市政污泥(固体浓度1-3%)对应约200-400㎡过滤面积,选1250型。计算时需预留20%余量应对污泥浓度波动和设备维护停机。
板框压滤机和带式压滤机哪个更适合高浓度工业废水?
板框压滤机适合固体浓度>1%的泥浆,滤饼含水率低(30-60%),单机处理能力大但批次运行;带式压滤机适合固体浓度0.5-2%的连续运行场景,自动化程度高但含水率偏高(65-80%)。高浓度污泥(SS>3g/L)或需要深度脱水至50%以下时,优先选板框压滤机。
板框压滤机滤饼含水率怎样才能降到50%以下?
需满足3个条件:①选板框隔膜压滤机(压榨压力1.5-2.0MPa);②进料污泥浓度>2%;③压榨时间比标准延长20-30分钟。中节能国祯环保科技股份有限公司项目数据显示,SSD化学改性结合板框隔膜压滤机可将污泥脱水至≤60%,进一步降低含水率需增加化学调理或热干化预处理。
全自动板框压滤机一般多少钱一台?
1250型PLC全自动型35-55万元(含不锈钢316L滤板),2000型PLC全自动隔膜压滤机50-120万元。价格差异主要来自机型规格、滤板材质、隔膜配置。中标价105万元的全自动机型通常包含全包维保服务。
板框压滤机滤板多久需要更换一次?
正常工况下PP滤板使用寿命5-8年,不锈钢滤板10-15年。出现滤板变形、密封面磨损或裂纹时应立即更换,否则会导致滤液浑浊和处理效率下降30%以上。滤板更换成本约为初始投资的15-25%,折算吨水成本0.05-0.15元。
延伸阅读





